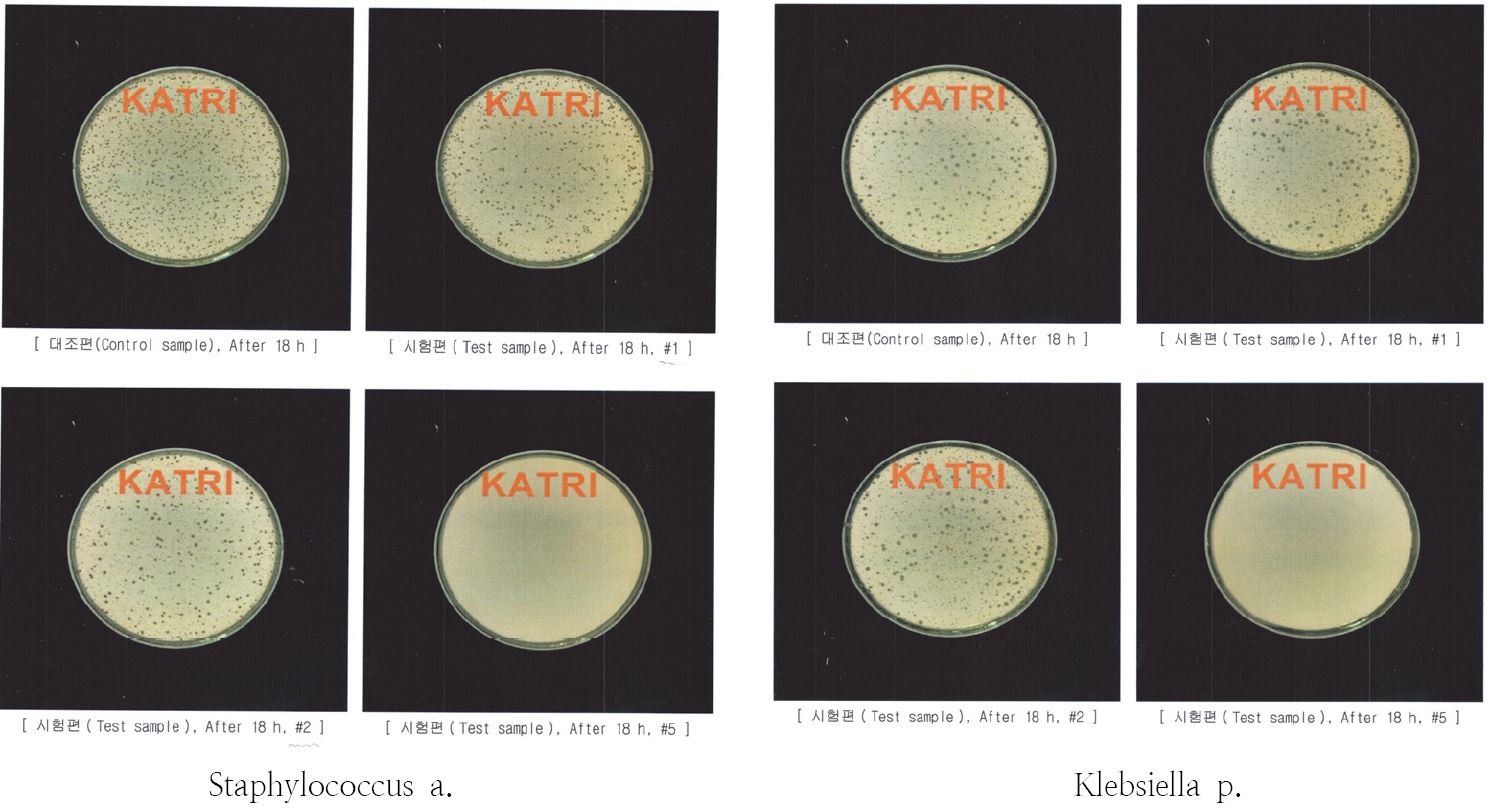
Fig. 5.

강황, 커피염색 면직물의 위생학적 성능과 Printing의 영향 평가


This is an Open-Access article distributed under the terms of the Creative Commons Attribution Non-Commercial License (http://creativecommons.org/licenses/by-nc/3.0) which permits unrestricted non-commercial use, distribution, and reproduction in any medium, provided the original work is properly cited.
Abstract
This study was conducted to develop fabrics using non-toxic and eco-friendly natural dyes made from curcuma and coffee extract. The natural dyes were applied to non-printed cotton fabrics using the dip dyeing method, and the pattern was hand-printed onto the dyed fabrics to make dyed printed-fabrics. The four types of developed fabric samples were compared to analyze the effects of the dyeing materials and printing on the hygienic properties of curcuma- and coffee-dyed fabrics. The findings were as follows. First, air permeability of both curcuma-and coffee-dyed fabrics was greatly affected by the presence of patterns, although the type of dye did not seem to have an effect. Printing greatly reduced air permeability of the fabric, and coffee-dyed fabric showed greater reduction of dyeing method than curcuma-dyed fabric. Moisture regain also tended to decrease with printing, but the change was much smaller compared to air permeability. Second, increased UV blockage was observed in curcuma- and coffee-dyed fabrics with patterns compared to non-printed fabrics, showing that printing enhanced UV blocking. Third, deodorization rate tended to increase sharply for both curcuma- and coffee-dyed fabrics until 30 minutes and gradually increased thereafter to yield 30% for curcuma and 50% for coffee at 120 minutes, demonstrating higher deodorization of coffee dye. Coffee-dyed fabric showed an antibacterial rate about twice as high as that of curcuma-dyed fabric, and the observed data suggest that curcuma-dyed fabric had an insignificant level of antibiosis. Fourth, printing significantly enhanced wash, sunlight, and compound colorfastness of the two types of dyed fabrics. The effect of printing was most dramatic on sunlight and compound colorfastness, which are aspects in which natural dyed fabrics perform poorly in general. Eventually, the development and application of biologically- and environmentally-friendly fabrics with natural dyes correspond with increased interest towards the wellness and healthy attitudes of modern society.
Keywords:
natural dyeing, curcuma, coffee, printing, hygienic propertiesI. 서론
최근 세계는 친환경 소재와 녹색소비를 지향하고 있고 웰빙, 로하스 생활양식을 선호하며, 슬로우 패션 운동이 점차 확대되는 가운데 천연염색이 주목받고 있다. 인공염료의 편리성, 다양성 및 견고성에도 불구하고 인공염료의 사용으로 인한 공해와 폐수 등의 환경오염 문제와 건강에 대한 관심 증대로, 인체에의 유해성, 천연염료 고유의 기능성, 염색기법의 발달로 그 다양성과 변화를 추구하는 현대인에게 천연염색은 더 선호되고 있다(Yoon 2009; Park 2012a). 또한 각종 천연염색 제품에 대한 수요 증가 추세는 천연염료를 이용한 섬유제품의 기능성 강화에 대한 연구와 다양한 관련제품 개발을 촉진시키고 있다(BIR Research Group 2012; Nam & Lee 2013).
천연염료는 대부분 식물에서 채취되는데, 천연 염재에서 추출한 염료는 인공염료로 염색한 염색직물에 비해 색상이 은은하여 자연스럽고 부드러운 느낌을 주며 환경에 친화적이고, 천연 염재는 한약재나 향료의 원료 또는 기호 식품 및 차와 음료로도 사용되고 있어 인체에도 친화적이다. 기능성 면에서도 항균, 소취, 항알레르기성, 혈액순환에 도움을 주는 장점에 관한 연구가 보고되어 있다(Sung 2011; Sa et al. 2014; Kang 2016). 반면 천연 염재는 색상의 재현성과 염착률이 낮고 염색 공정이 수공적인 부분이 많아 대량생산에 한계가 있고 염재의 확보와 저장 등이 어려우며, 특히 견뢰도에 취약하여 그 방면의 연구와 개선의 여지가 많다(Park 2002; Kim & Shin 2011; Park 2012b; Sa et al. 2014). 그렇지만 자연에서 손쉽게 얻을 수 있는 천연 염재나 재활용할 수 있는 염재들도 있다. 이 중에서 황색계의 염재로는 치자, 강황 및 울금, 황벽 등이 있고, 갈색계로는 감즙, 커피, 밤, 도토리 등이 있으며 이들은 약용, 식용 색소로도 많이 사용되어지고 있다.
대표적 황색계 염재인 강황은 생강과에 속하는 다년생 초본식물로 인도가 원산지이며 세계의 재배량 및 생산량의 94%가 인도산으로 특유의 향이 있는 카레의 주원료이다. 강황의 주성분은 탄수화물, 정유성분, 단백질로 알려져 있으며(Senthikmar. et al. 2014) 그 중 커큐민(curcumin)이 90%를 차지하고 있다. 강황 색소의 주성분인 커큐민의 폴리페놀(polyphenol) 성분은 노란색의 향신료 및 색소로 사용되며 약리적 효과로 살균력을 가지고 있어 항염증 및 통증완화, 항균 효과, 항산화 및 뇌세포 활성화로 치매예방, 혈액순환의 촉진 등 효과가 있는 것으로 알려지고 있으며, 직물과 종이 염색에는 물론 한방의약품, 한방식품, 한방화장품, 한방비누 등 다양한 원료의 색을 내는 물질로 이용되고 있다(Kwak et al. 2008; Sung 2011; Jung et al. 2012; Senthikumar et al. 2014; Lee et al. 2016). 그러나 강황추출물의 염색성과 기능성을 확인한 연구는 극소수에 불과한 실정이다(Kang 2016).
갈색계인 커피는 실생활에서 쉽게 접할 수 있는 타닌(tannin)계의 다색성 염재(polygenetic dyes)로 염색 메커니즘은 염재 중에 포함된 염료에 따라 모두 다르다(Lee & Ko 2016). 커피는 현대인의 기호식품 중의 하나로 성분은 회분, 지방, 당분, 타닌, 단백질 및 카페인으로 구성되어 있다. 기본 골격이 폴리페놀 구조로 주 색소성분으로는 타닌계 색소의 클로로겐산이며 대부분 가수분해형이다(Jung 2006). 이 성분 중의 타닌과 단백질이 있어 염료로서 적합하여 직물 염색뿐만 아니라 염모제로서의 가능 여부의 연구도 시도되고 있다(Yoon 2008). 또한 커피는 볶음으로써 카페인과 타닌의 양은 감소하나 단백질의 양은 증가하며(Yoon 2009), 타닌은 풀을 제외한 대부분의 식물에 있어서 자체의 세균 등에 대한 방부적 보호 작용을 위하여 존재하는 것으로 알려져 있다(Jung 2006). 또한 최근에 커피는 마시는 음료뿐만 아니라 하나의 문화로도 자리 잡기에 이르렀다. 그리하여 본 연구에서는 이러한 커피를 식용뿐만 아니라 재활용의 의료(衣料)로서의 활용가능성을 탐색하고 인체에 착용할 수 있도록 직물 염색에 이용하여 슬로 패션 마인드의 일환으로 친환경적인 의류소재를 개발한 후 그 위생학적 성능을 평가하고 염색견뢰도의 개선방법을 검토하고자 한다.
커피는 강황과 같이 인체에 이로운 기능성이 있는 것으로 알려져 있고, 항산화, 항암, 항균성, 뇌신경세포 형성 촉진, 이뇨작용, 기억력 증진, 각성의 효과, 노화 억제, 냄새 제거, 염증 억제 등의 약리적 효능이 연구에 의하여 밝혀지고 있으며(Jung 2006), 최근에는 커피 속의 카페인이 염증 억제 효과가 있음이 입증되었다(미국 하버드대학 연구팀, KBS 뉴스 2017. 1.18). 또한 기능성으로는 항균성과 소취성이 있는 것으로 알려져 있고 우리 생활에서 쉽게 얻을 수 있는 커피 찌꺼기는 천연퇴비를 만들어 쓰는 친환경적인 재료로 쓰이기도 한다. 이와 같이 강황과 커피는 염색성 및 위생학적 기능성과 고유의 향이 있어 식재료로 사용하다가 오래된 것은 염재로 이용할 수 있고, 특히 커피 찌꺼기는 퇴비의 원료나 소취제, 염모제로도 재활용할 수 있는 순환형 친환경적인 재료라는 장점이 있다.
그러나 이들 천연 염재를 이용한 염색에 관한 연구는 극소수에 불과하고 강황 염색은 울금과 함께 연구되기도 하나, 커피를 이용한 직물 염색은 거의 찾아볼 수 없다. 또한 printing 염법은 인공염료 또는 안료가 직물표면에 집중적으로 고착되어 있으므로 피부에 직접 닿지 않기 때문에 피부 장해 문제로부터 어느 정도 벗어날 수 있는 염색방법이다(Kim & Shin 2011). 그러므로 본 연구에서는 천연염색 중에서도 연구가 매우 미흡하고 재활용이 가능한 이 두 종류의 천연 염재를 선택하여 그 염색포의 위생학적 성능을 실험을 통하여 검증하고 printing 염법이 미치는 영향을 평가하고자 한다. 또한 현 시대가 지향하는 다품종 소량화 시대에, 다양성을 추구하고 소재의 실용성을 높이기 위하여 염색견뢰도를 개선하고자 염색견뢰도에 미치는 printing의 효과도 밝히고자 한다.
Ⅱ. 연구방법
1. 시료 제작
시료는 시판 직물 중 표준면과 실제로 일치하는 평직의 면직물을 선택하여 강황과 커피 염재만 달리한 2종의 무지 염색포를 각각 5마를 제작한 후 각 1/2 분량에는 나뭇잎 모양의 문양을 직접 그려 넣는 방법으로 printing하여 무늬염색포를 제작, 시료로 하였다. 무늬염색포는 영향이 예상되는 측정항목을 중심으로 실험 시 시료로 사용하고 소취성과 항균성은 염재 자체만의 기능성을 비교하기 위하여 무지염색포만 시료로 하여 비교, 분석하였다.
2. 염색
염색은 2016년 11월 12일부터 12월 4일에 걸쳐 행하였다. 본 연구의 목적이 인공적인 요소를 최소화하는데 있으므로 시료의 정련은 전통적 천연 염색에서 흔히 하는 방법인 세탁기를 이용한 물세탁으로 하였다. 강황과 커피는 다색성 천연 염재이므로 매염제에 의해 색상이 변하는 것을 방지하기 위하여 천연 매염제인 명반 이외의 매염제는 사용하지 않고 최대한 무매염에 가까운 침염법으로 염색을 하였다. 제작한 무지염색포에 문양을 직접 그려 넣는 방식(묘염법)으로 프린팅을 하여 무늬염색포를 제작하였다. 염색은 다음과 같은 절차와 방법으로 행하였다.
(1) 강황
강황(curcuma longa L.)의 염액은 시판되는 인도산 100%의 강황 분말 15 g을 체로 걸러 5,000 mL(피염물 무게의 25배)의 물에 넣고 교반함으로써 균일하게 용해시켜 추출하였다. 염색은 전통적 방법과 Song(1996)의 직접염료에 의한 면의 염색 일반 방법에 기초하였으며, 시료의 정련은 간략하게 세탁기를 이용한 물세탁으로 하여 건조시켰다. 그 다음에 추출한 염액을 가열하여 약 40℃에 달했을 때 명반 양의 1/5과 직물을 염액에 침지하였다. 온도를 올리면서 명반을 5분 간격으로 4차례에 걸쳐 나누어 넣고 90℃ 이상의 온도에서 약 30분간 염욕에 처리하여 1회 염색한 후 수세, 건조시켰다. 이는 면직물의 염색 시간은 40분이 염착도가 가장 좋다는 연구결과를 참고로 한 것이다(Yoon 2009).
염재용 커피(coffee arabica)는 시판되는 것으로, 오래되어 식용이 불가능한 르완다산 100% 아라비카 품종의 작은 알갱이가 있는 커피(naturally crop) 분말을 재활용하기 위하여 필터로 거른 후 염액용으로 사용하였다. 염액은 강황과 동일한 방법으로 물 5,200 mL에 커피 분말 105 g을 용해시켜 염액을 추출하였다. 이 염액에 면직물을 침지하여 1회 염색한 후 수세, 건조시켰다.
이와 같은 방법으로 제작한 강황(S1)과 커피(S2) 2종의 무지염색포에 문양을 넣기 위하여 시판되는 자카드텍스타일(미국산 텍스타일용 물감, ASTM D4236-89 무해 인증코드)에 텍스타일 페인팅용 직물보조제(텍스타일 미디엄, 한국)를 소량 혼합하여 디자인한 나뭇잎 문양을 수작업으로 printing하여 강황 무늬포(S3)와 커피 무늬포(S4) 2종을 제작하였다. 문양의 색상은 동일하게 Brown Color(127 RUSSET)로 하였다(Fig. 1).
3. 시료의 특성 실험 및 분석 방법
KS K ISO 9237(1995)에 의하여 면적 20 ㎠, 정압 100 pa 조건에서 공기투과도시험기(Textest Co., Switzerland)로 5회 이상 측정하고, 무늬염색포 시료는 printing된 부분을 중심으로 측정하여 무지염색포와 무늬염색포의 통기성의 차이를 비교하였다. mm/s의 값으로 측정하였는데 측정값×6을 하면 ㎤/min/㎠로 환산이 가능하다.
KS K 0220(2016) 오븐법에 의해 표준상태(20℃, 65% RH)의 항온항습기(Wiess Co., Germany)에서 각 시료당 2매씩 채취하여 반복 실험한 값의 평균치로 하고, 무늬포 시료는 printing된 부분과 되어 있지 않은 부분이 혼재하여, printing된 부분을 중심으로 측정하였다.
시료크기 1×3 cm 정도로 측정기기 UV Transmittance Analyzer (Labsphere Co., USA)로 광원은 Xenon Arc에 의해 KS K 0850(2014)에 준용하여 인체에 가장 심각한 해를 미치는 범위인 파장 A(315-400 nm)영역과 B(290-315 nm) 영역의 광선투과도를 측정하고 자외선 차단율을 산출하여 비교하였다.
Gastec(일본)을 이용하여 시료 크기 10×10 ㎝, 환경 21℃, 49% RH 상태에서 가스검지관법에 의해 500 ppm의 암모니아(NH₃) 가스를 주입하여 시간대별로 각 시료의 소취율을 측정하였다. 가스검지관법은 1 L의 유리병에 뚜껑을 닫고 주사기(눈금 1.6 ~ 2.0)를 사용하여 암모니아 용액을 주입하고 30분간 시험실에 방치한 다음, 채취한 시험편을 비커 4개에 각각 넣어 뚜껑을 닫고 주사기를 사용하여 Blank에 사용했던 암모니아 용액의 양과 같게 주입하여 측정하는 방법이다. 30분, 60분, 90분, 120분 방치 후 가스검지관의 눈금을 확인하는 방법으로 양을 측정하였다.
소취율과 항균율은 염재 고유의 성능을 파악하는데 목적을 두어 측정하고자 문양의 영향을 배제하기 위하여 강황과 커피 무지염색포 시료만으로 측정하여 다음 식에 의해 계산하였다.
A: Blank 가스 농도
B: 염색포의 가스농도
항균성을 추출하기 위하여 KS K 0693(2011)에 의거 시험하였는데, 균배양은 뉴트리언트 한천 평판배지에서 배양한 시험균을 뉴트리언트 액체 배지에 접종하여 진동 배양한 후, 20배로 희석한 뉴트리언트 배지에서 생균수가 0.7~1.3개/mL가 되도록 조제하여 접종원으로 하였다. 시험편의 크기는 0.4 g으로 하고 항균가공 제품과 대조시험편에 배양한 시험균을 0.2 mL씩 접종하여 약 18시간 배양 후 생균수를 측정하여 항균 가공 제품과 대조시험편을 비교하였다.
대조시험편은 표준면포(KS K 0905(2015))로, 시험균은 2종으로 ① Staphylococcus aureus ATCC 6583(황색포도상구균)과 ② Klebsiella pneumomiae ATCC 4535(폐렴균)을 사용하였고, 비이온계면활성제 Tween 80(Junsei Chemical Co., Japan)을 접종균액의 0.05% 첨가하여, 강황과 커피의 무지포에서만 측정, 다음 식에 의해 정균감소율을 계산하였다. 접종균액의 농도는 시험균 ①은 1.1 × 105 CFU/mL, ②는 1.2 × 105 CFU/mL로 하였다.
A: 대조시험편의 18시간 후의 균수
B: 염색포의 18시간 후의 균수
본 연구에서 필요하다고 판단된 세탁, 땀, 일광, 복합견뢰도 시험을 행하였다.
(1) 세탁견뢰도
KS K ISO 105-C06(2014)의 A2S호에 의하여 40 ± 2 ℃에서 30분간, ECE 표준세제(인산염이 있는 세제)를 사용하여 4종의 시료를 Launder O meter(아세아기공, 한국)로 세탁하고 이염 또는 변퇴정도를 급수로 판정하여 염색의 종류와 염색포의 문양 유무별로 비교, 분석하였다. 이하 4종의 염색견뢰도 시험에서 시료 S3, S4인 무늬염색포에서는 모두 짙은 색의 문양 부분을 중심으로 측정하였다.
(2) 땀 견뢰도
KS K ISO 105-E04(2015)에 의하여 37 ± 2 ℃에서 4시간 동안의 시험으로 산과 알칼리성 인공 땀액에서 이염 또는 변퇴정도를 급수로 판정하고 염색의 종류와 염색포의 문양 유무에 따라 비교, 분석하였다.
(3) 일광견뢰도
KS K ISO 105-B02(2015)에 의하여 미국의 ATLAS사 시험기로 Xenon Arc로 수냉식, 방법3 표준청색포에 의하여 시험하였다.
(4) 복합견뢰도
KS K 0701(2014) B법(Xenon법)에 의거, 미국의 ATLAS사 시험기로 땀 및 일광의 복합작용에 의한 염색견뢰도를 시험하였다.
III. 결과 및 고찰
1. 공기투과도
공기투과도(통기성)는 염재의 종류에 따른 차이는 크지 않으나 무지포와 무늬포에서 강황>커피 염색포 순으로 나타났고, 문양의 유무에 따라서는 큰 차이를 보였다. 강황 염색포는 무지포(S1)>무늬포(S3), 커피염색포도 무지포(S2)>무늬포(S4) 순으로 나타났다. 문양 유무에 따른 두께의 변화가 없음에도 공기투과도는 문양을 넣음으로써 크게 감소하였다. 강황의 무지염색포는 821.0 mm/s에서 무늬염색포는 346.9 mm/s로 57.8% 감소하였고, 커피의 무지염색포는 784.3mm/s에서 무늬염색포는 262.7 mm/s로 66.5% 감소하여 강황 무늬염색포보다 커피 무늬염색포에서 감소량이 더 크다는 것을 알 수 있었다(Fig 2).

Effects of printed patterns on air permeability of curcuma- and coffee-dyed fabrics.S1: curcuma-dyed non-printed fabricS2: coffee-dyed non-printed fabricS3: curcuma-dyed printed fabricS4: coffee-dyed printed fabric
반면, 천연 감즙염색에 의해서는 동일한 면직물의 무지염색포, 무늬염색포에서 모두 공기투과도가 증가하여 통기성이 좋아지는 것으로 나타났다(Park 1995; Park 2012b). 그 이유는 감즙염색포가 다른 천연염색포와는 다르게 감즙염색을 함으로써 푸새를 한 것과 같이 뻣뻣해지는 특성이 나타나므로, 이 성질이 문양을 덧입힌 부분적인 printing 효과보다 바탕 전체에 염색된 감즙염색의 효과가 더 커서 문양에 관계없이 무지염색포와 무늬염색포에서 공기투과도가 증가한 것으로 추정된다.
이와 같이 공기투과도는 천연염료의 종류에 따라 문양의 유무에 있어서도 다른 결과가 나타남을 알 수 있었다.
2. 수분율
수분율(흡습성)은 무지염색포에서 염재의 차이는 나타나지 않았고(S1과 S2: 7.6%), 두 무지염색포에 문양을 넣음으로써 감소하는 경향은 뚜렷이 나타나, 강황은 무지염색포(S1) 7.6%에서 무늬염색포(S3)는 5.72%로 24.8% 감소하였고, 커피는 무지염색포(S2) 7.6%에서 무늬염색포(S4) 5.78%로 24.0%의 감소율을 보였다. 수분율에서는 공기투과도보다 감소량이 훨씬 작게 나타났다(Fig. 3). 따라서 강황과 커피 무지염색포에 문양을 넣음은 공기투과도와 수분율의 감소를 가져와 문양의 밀도와 면적이 클수록 한여름의 의복소재로서는 쾌적성을 낮추는 요인이 될 수 있을 것으로 추정된다.

Effects of printed patterns on moisture regain of curcuma- and coffee-dyed fabrics.S1: curcuma-dyed non-printed fabricS2: coffee-dyed non-printed fabricS3: curcuma-dyed printed fabricS4: coffee-dyed printed fabric
그러나 다른 천연염재인 황토 날염에서는 황토의 농도가 높을수록 수분율이 증가하였다(Shin et al. 2007). 이는 황토 염재의 구조가 벌집구조로 수많은 복층구조를 이루고 있어 이 스폰지와 같은 구멍이 있는 구조가 수분을 흡수, 저장할 수 있기 때문으로 추측된다. 또한 감즙염색에 의해서는 수분율이 백포 무늬포가 7.5%인데 비해 염색 무늬포는 9.2%로 높아져 22.7% 증가하는 것으로 나타났다(Park 2012b). 이는 감즙염색 후의 푸새 효과로 뻣뻣한 성질이 나타남과 염색으로 인하여 경사, 위사가 달라붙어 공간이 생긴 것(Park 1995)에 기인한 결과로 보인다.
이와 같이 천염염색포는 염재의 종류에 따른 염색구조의 차이에 의해 공기투과도와 수분율이 증감할 수 있다는 것을 알 수 있었고, 통기성과 흡습성의 증감에 따라 천연염색 소재의 의복을 착용했을 때의 쾌적감도 그 염색의 종류에 따라 달라질 수 있다는 것을 추정할 수 있다.
3. 자외선 차단율
자외선 차단율은 Table 1에 제시한 바와 같이 염재의 차이로 검토해볼 때 무지염색포에서는 자외선 A영역(UVA)에서 강황(S1)≥커피(S2)로 나타나고 무늬염색포에서는 커피(S4)≥강황(S3) 순이지만 모두 미미한 차이에 불과하다. 자외선 B영역(UVB)에서는 무지염색포 및 무늬염색포에서 커피≥강황 순으로 커피가 근소하게 큰 것으로 나타났다. 그러나 문양의 유무 차이로 검토하면 2종의 무지염색포 강황(S1), 커피(S2)보다 무늬염색포 강황(S3), 커피(S4)에서 뚜렷이 증가함을 알 수 있다. 즉 UVA에서 강황은 S3(95.9%)>S1(89.6%), 커피는 S4(96.7%)>S2(88.6%)로 무늬염색포가 증가하였다. UVB에서도 강황이 S3(96.1%)>S1(88.2%), 커피가 S4(96.9%)>S2(88.9)로 2종 모두 무늬염색포가 무지염색포보다 자외선 차단율이 높은 것으로 조사되어 printing의 도입은 강황과 커피 염색포 모두 차외선 차단 기능을 향상시키는 것으로 조사되었다. 이 결과는 염재의 차이보다는 문양의 유무에 따른 차이가 더 뚜렷하게 나타남을 보여주고 있다. UVA는 파장이 길어 피부에 깊숙이 침투하여 피부의 탄성섬유와 콜라겐의 붕괴로 탄력 감소, 조기 노화 및 피부암을 유발할 수 있다. UVB는 진피상부층까지 도달하고 급속한 화상이나 홍반을 일으켜 인체 피부에 해를 가져오므로 자외선으로부터 피부를 보호하기 위한 방법으로 의복, 모자, 양산 등 의류에 차단 기능을 증진시킨 제품이 개발되고 있다.
자외선 차단율의 증가현상은 다른 천연염색포에서도 나타났는데, 녹차염색의 견, 마직물에서는 염색 횟수가 증가할수록 자외선 차단율도 증가하여 정적 상관관계를 보였다(Song & Song 2005). 또한 감즙염색 면직물에서는 전통적 방법인 1회 염색 후 햇빛에 반복 노출로 발색시키는 방법으로 제작한 무지염색포와 무늬염색포에서 모두 증가현상을 보였다(Park 1995; Park 2012b). 이 결과로부터 염색을 하면 색이 짙어지므로 문양의 유무보다 농색으로 염색되는 천연염색포일수록 자외선 차단성도 증가하는 것으로 추정할 수 있다.
이와 같이 천연염색 가공 의류소재 중에 자외선 차단 기능성이 있는 염재로 염색하여 제조된 제품들이 알려지면서, 이후에는 이외에도 점차 새롭고 다양한 천연염색 의류소재의 개발 가능성이 높아질 것이다. 따라서 자외선 차단 효과를 검증하여 자외선으로부터의 피해를 최대한 줄이기 위한 지속적인 연구가, 온난화가 가속화되는 현대에는 더욱 필요하다고 생각된다.
4. 소취율
소취율에서는 염재 자체의 소취기능 파악에 초점을 두어 살펴보고자 강황과 커피 염색 무지포만을 비교하였다.
강황과 커피염색을 한 면직물의 0-120분까지 시간경과에 따른 암모니아 가스 농도의 감소효과를 Fig. 4 그래프로 볼 때 두 샘플에 있어 30분 경과까지는 급속히 감소하여 가스농도는 30분 경과 시 강황 380 ppm과 커피 300 ppm, 60분 경과 시 강황 370 ppm과 커피 280 ppm을 보이며, 90분 경과 시에는 강황 360 ppm과 커피 260 ppm을, 120분 경과 시에는 강황 350 ppm과 커피 250 ppm을 나타내었다(Fig. 4a). 이에 따라 소취율은 30분 경과까지는 강황염색포가 24%, 커피염색포가 40%로 급격한 증가를 보였다. 30분 이후부터는 완만한 증가를 보여 60분에서는 강황 26%와 커피 44%, 90분경과 시는 강황 28%와 커피 48%, 120분경과 시에는 강황 30%와 커피 50%의 소취율을 보였다(Fig. 4b). 두 염색포의 소취율을 시간경과에 따라 비교했을 때 커피염색포의 소취율이 휠씬 높아 2시간 후에는 강황염색포보다 60% 큰 것으로 나타났고, 시간 경과에 따른 소취율의 증가율도 강황에 비하여 높게 나타났다. 이 실험의 결과는 커피가 일상생활에서도 악취를 제거하는데 활용되고 있는 이유를 잘 뒷받침해주고 있다.

Changes in deodorizing concentrations according to times of curcuma(S1)- and coffee(S2)-dyed samples.S1: curcuma dyed non-printed fabricS2: coffee dyed non-printed fabric
이 외 소취성이 있는 것으로 알려진 천연염료로 숯염색이 있는데, 숯은 다공성 물질로 흡착성이 있어 악취제거에 활용되고 있다. 이런 특성이 있는 숯으로 날염 가공한 폴리프로필렌(a)과 폴리에틸렌 부직포(b)와 소취성을 비교해 보았을 때, 30분까지 급격한 증가를 보이고 이후 완만한 소취율을 보인 패턴도 본 결과와 동일하였다. 120분후에는 숯 3%농도에서 a:52%, b:46%를 나타내었고 9%농도에서는 a:89%, b:83%까지 증가하여 염착농도가 클수록 탈취율도 크게 향상되어 본 연구 결과와 일치함을 알 수 있었다(Shin et al. 2004; Jo & Lee 2005). 그러나 강황, 커피, 숯 염색포의 소취율을 비교할 경우는 숯 염색포가 가장 높고, 다음으로 커피염색포로 나타났으며 강황염색포의 소취율은 미미한 것으로 나타났다. 또한 단삼 염색의 견직물에서도 염색포의 소취율이 미염포보다 높게 나타나 소취율이 매우 우수한 것으로 나타났다(Nam & Lee 2013).
날염의 경우는 염료가 섬유표면에만 염착되기 때문에 날염에 의한 염색포가 소취성이 낮게 나타나는 경우도 있으나(Nam & Kim 2010), 본 강황과 커피염색포의 결과는 프린팅을 배제한, 염료가 내부까지 침투되는 침염포에 의한 결과이므로 염재의 특성에 따른 차이로 판단된다. 앞으로 천연염재의 소취성과 같은 기능성은 연구가 활발히 진행되면서 계속 밝혀질 것으로 예측되므로 염색뿐만 아니라 일상생활에서 천연염재의 활용분야는 점차 확대될 것으로 전망된다.
5. 항균율
항균율에서도 염재의 종류에 따른 항균성 파악에 초점을 두고 살펴보고자 강황과 커피 염색 무지포만을 비교하였다. 황색포도상구균(S. aureus)과 폐렴균(K. pneumoniae)을 사용하여 강황과 커피의 무지염색포에서 항균성을 측정하고, 타 천연염색포의 항균성에 대한 비교와 고찰을 위하여 감즙염색 무지포의 항균성도 동시에 측정하였다. 그 결과를 Table 2와 Fig. 5에 제시하였다.
Photographs of cultured Staphylococcus(left) and Klebsiella(right) after 18h.① Upper Left: Control ② Upper Right: dyed fabric with curcuma ③ Lower Left: dyed fabric with coffee④ Lower Right: dyed fabric with persimmon juice(both Staphylococcus and Klebsiella)
Table 2에서 보는 바와 같이 커피염색포가 황색포도상구균에서 81.8%로 강황염색포 44.0%보다 항균성이 2배 가까이 높은 것으로 나타났으나 폐렴균에서는 강황은 항균성이 거의 나타나지 않았고 커피염색포도 미미한 것으로 나타났다. 강황염색포는 항균효과가 있는 것으로 알려져 있으나(Sung 2011; Kang 2016) 본 연구에서는 항균성이 미미한 것으로 조사되었다. 울금 색소 추출물의 경우, 71%의 황색포도상구균 성장억제 효과를 나타낸 연구도 있어(Han & Choi 2001), 본 강황의 결과보다는 항균성이 높은 것으로 조사되었으나 심황계(tumeric: 강황, 울금)의 항균성은 그다지 있지 않은 것으로 판단된다. 일반적으로 항균율이 80% 이상 되어야 항균성이 좋다고 판단하고 99% 이상이면 우수한 것으로 인정하고 있다.
반면, 예로부터 항균성이 있다고 알려진 감즙염색포를 동일한 균으로 동시에 시험한 결과, 항균율은 포도상구균과 폐렴군에서 99.9%로 조사되어 감즙은 항균성이 매우 우수한 천연염재임이 확인 되었다. 감즙염색포는 전통적으로 방부효과가 있어 잘 썩지 않아 관리가 용이하고 위생적이라고 일컬어져왔는데(Park et al. 1999), 본 실험에서 그 특성을 재확인할 수 있었다. 그 외 천연염색포의 항균성은 숯, 황토로 날염가공한 폴리프로필렌 및 폴리에틸렌 부직포에서도 높은 항균성을 보여 농도 3% 이상에서는 숯, 황토 모두 항균율이 99.9%로 나타나(Shin et al. 2004; Shin et al. 2007), 숯과 황토는 이들 염료로 날염한 합성 부직포에서도 99.9%를 보여 대단히 우수함을 알 수 있다. 또한 쑥 염색 면직물의 항균성은 쑥의 물을 추출하여 무매염으로 염색했을 때 보다 에탄올을 첨가했을 때 S. aureus균에 대한 항균성이 우수하고 세탁 후에도 유지되는 것으로 나타났다(Shin & Chung 2013). 또한 차가버섯 추출물 염액의 면직물 염색포에서도 97.9~99.9%의 항균성을 보였고(Kim 2009), 소루쟁이 뿌리와 달맞이꽃 추출액을 이용한 면직물 염색에서도 포도상구균 99.9%, 폐렴균 50%의 우수한 항균성을 나타내었다(Han & Lee 2009; Seo et al. 2011). 부가하여 유백피 추출액을 이용한 면직물 염색에서도 슈퍼박테리아에 대한 항균효과가 유의하게 세균성장을 억제하는 것으로 나타났다(Choi & Kang 2015). 이와 같이 여러 가지 식물 염재에서 우수한 항균성이 밝혀지면서 천연 식물 염색은 의약학 분야, 병원, 실험실 등 균에 노출되기 쉬운 환경의 작업복이나 실험복 소재에 쓰일 가능성도 기대해 볼 수 있다.
7. 염색견뢰도
염색견뢰도는 Table 3에서 보는 바와 같이 강황과 커피 염색포에 문양을 넣음으로써 두 시료에서 세탁, 일광, 복합견뢰도 모두가 향상되었다. 세탁견뢰도는 강황, 커피 모두 무지염색포가 3등급에서 무늬염색포는 4등급으로 향상되었다. 특히 천연염색포가 견뢰도면에서 취약하여 문제시 되고 있는 일광과 복합견뢰도에서도 크게 향상되었는데, 일광견뢰도는 강황, 커피 두 시료 모두 무지염색포 1등급에서 무늬염색포 4등급으로 향상되었고, 복합견뢰도에서도 2종의 무지염색포가 2-3등급인데 무늬염색포는 4-5등급으로 뚜렷하게 향상되었다. 이 결과는 천연염색을 한 침염포 위에 인공염료가 부분적으로 덧입혀지는 구조의 문양을 부가함으로써 일광>복합 견뢰도 순으로 크게 향상됨을 보여주고 있다. 또한 세탁견뢰도와 땀견뢰도에서 오염편은 모두 4-5급으로 나타나 이염은 전혀 시키지 않는 것으로 나타났다. 감즙염색을 했을 경우에도 감즙염색 무지포는 일광견뢰도가 1-2급, 복합견뢰도가 2-3급에서 감즙염색 무늬포는 일광견뢰도와 복합견뢰도가 모두 4급으로 향상되어(Park 1995; Park 2012b) 동일한 결과가 나타났다.

Colorfastness of dyed fabrics and dyed printed-fabrics on washing, sweat, sunlight, and compound(grade)
염색견뢰도를 높이는 방법으로써 매염제를 사용한 연구는 다양하게 진행되어왔다. 그러나 printing을 적용하여 견뢰도를 시험한 연구는 극소수에 불과한데, printing을 함으로써 산성, 알칼리성 땀 견뢰도가 우수하다는 연구(Nam & Kim 2010)와 키토산 천연색소의 농도 변화와 printing을 통하여 염색견뢰도가 향상됨을 밝힌 연구가 있을 뿐이다(Kim & Shin 2011).
천연염색 자체가 전통적인 방법으로 수공으로 이루어지는 경우가 아직도 많아 문양을 활용하는 방법은 실용성이 있을 것으로 예측되므로, 본 연구에서는 자연 그대로의 색상을 유지하기 위하여 다른 매염제는 거의 쓰지 않고 천연 염색포에 인공염료에 의한 문양을 더하는 방법을 이용하여 부분적으로 문양을 넣는 방법으로 인공염료가 피부에 직접 닿지는 않으면서 견뢰도를 높일 수 있는 하나의 개선 방법을 제시하고자 하였다.
Ⅳ. 요약 및 결론
본 연구에서는 인체에 무해하고 환경에 친화적인 천연 염재로 의류소재를 개발하고자, 식용재료이면서 고유의 향이 있으며 재활용이 가능한 천연의 강황과 커피로부터 염액을 추출하여 침염법으로 면(cotton)무지 염색포를 제작한 후, 이 무지염색포에 문양을 수작업으로 printing하여 무늬염색포를 제작하였다. 제작한 4종의 염색포를 시료로 염재의 차이와 문양의 유무에 따라 무지염색포와 무늬염색포의 통기성과 흡습성, 자외선 차단성, 염재에 따른 소취성, 항균성의 위생학적 성능 및 실용성을 위하여 염색견뢰도를 비교, 분석하였다. 그 결과를 요약하면 다음과 같다.
첫째, 통기성은 강황, 커피 염색포에서 염재에 따른 차이는 미미하고 문양의 유무에 따른 차이는 뚜렷이 나타났다. 문양을 넣음으로써 공기투과도는 크게 감소하였는데, 커피염색포가 강황염색포보다 감소량이 더 크게 나타났다. 흡습성에서도 printing을 적용함으로써 감소하는 경향을 보였으나 그 차이는 통기성보다 훨씬 작게 나타났다.
둘째, 자외선 차단율은 강황과 커피로 염색한 2종의 무지염색포에서보다 무늬염색포에서 더 증가하여 염재의 차에 의한 요인보다 printing에 의해 차외선 차단성이 더 향상됨을 알 수 있었다.
셋째, 소취율에서는 두 시료 모두 30분 경과까지는 소취율이 빠르게 증가하는 경향이 있었고 이후에는 완만한 증가를 보여 120분경과 시에는 커피염색포가 강황염색포보다 60% 큰 것으로 나타났다. 항균율은 커피 무지염색포가 강황 무지염색포보다 약 2배 높은 것으로 나타났으며, 강황염색포는 항균성이 미미한 것으로 조사되었다.
넷째, 염색견뢰도는 강황과 커피 염색포에 printing 염법을 적용함으로써 세탁, 일광, 복합견뢰도 모두가 향상되었다. 천연염색포가 특히 취약한 일광과 복합견뢰도가 크게 향상되어 문양의 효과가 가장 잘 나타났다.
궁극적으로 인체에 무해하고 환경에 친화적인 천연 염료를 이용한 의류소재를 개발하여 실생활에 활용하는 것은 건강한 생활을 지속하고자 하는 일종의 라이프스타일로, 최근 확대되고 있는 슬로우 패션 마인드와도 방향을 같이 한다고 할 수 있을 것이다.
Acknowledgments
This research was supported by grants from National Foundation of Korea(NRF-2016S1AB5A07915867).
References
- BIR (Business Information Res) Research Group, (2012), R&D Themes green technology, pioneering convergence technologies, Seoul, Author.
-
Choi, NY, Kang, SY, (2015), Effect of Ulmus Davidiana var. Japonica Nakai Extract on Antibiotic Resistant Bacteria in dyed cotton, J Korean Soc Cloth Text, 39(2), p287-293.
[https://doi.org/10.5850/jksct.2015.39.2.287]

-
Han, MR, Lee, JS, (2009), Natural dyeing of cotton fabrics with Rumex crispus L. Root, J Korean Soc Cloth Text, 33(2), p222-229.
[https://doi.org/10.5850/jksct.2009.33.2.222]

- Han, SY, Choi, SC, (2001), Antibacterial activity and identification of the active compound from tumeric extract, Text Coloration Finish, 14(1), p11-17.
- Jo, WJ, Lee, JS, (2005), Dyeing of silk fabrics using charcoal, J Korean Soc Cloth Text, 29(2), p279-285.
- Jung, SK, (2006), Dyeability of silk using coffee, Master’s Thesis, Pusan University, p1-4.
- Jung, YS, Park, SJ, Park, JH, Jhee, KH, Lee, IS, Yang, SA, (2012), Effect of Ethanol Extracts from Zingilber officinale Rosc., Curcuma longa L., and Curcuma aromatica Salisb. on Acetylchloinesterase and Antioxidant Activities as well as GABA Contents, J Korean Soc Food Sci Nutr, 41(10), p1395-1401.
- Kang, S, (2011), Dyeability and the applied research on Nanofiber using Curcumae longae Rhizoma extract, Master’s Thesis, Chungnam University, p1-4.
-
Kim, CY, Shin, YS, (2011), Eco-printing using chitisan and natural colorants(1), Text Coloration Finish, 23(2), p90-99.
[https://doi.org/10.5764/tcf.2011.23.2.90]

-
Kim, SH, (2009), Dyeing properties and antibacterial activity of cotton fabrics with inonotus dbliquus, J Korean Soc Cloth Text, 33(11), p1774-1780.
[https://doi.org/10.5850/jksct.2009.33.11.1774]

- Kwak, MJ, Kwon, JS, Lee, SH, (2008), Natural dyeing of Chitosan-crosslinked cotton fabrics, Text Coloration Finish, 20(3), p8-17.
-
Lee, YH, Park, YK, Baek, YM, Kim, JS, Lee, DJ, Kim, HD, (2016), Effect of extractant on the color characteristics of natural colorant extract, Text Coloration Finish, 28(1), p1-12.
[https://doi.org/10.5764/tcf.2016.28.1.1]

-
Nam, JR, Lee, JS, (2013), Natural dyeing of silk fabrics with Dansam (Salvia miltiorrhiza Bunge) Extract, J Korean Soc Cloth Text, 37(7), p874-881.
[https://doi.org/10.5850/jksct.2013.37.7.874]

-
Nam, SW, Kim, KT, (2010), Preparation and screen printing of natural dye powders, Text Coloration Finish, 22(4), p314-324.
[https://doi.org/10.5764/tcf.2010.22.4.314]

- Park, DJ, Park, SJ, Ko, JS, (1999), Dyeing of fabrics with immuture persimmon juice -effect of dyeing assistants and ultraviolet rays treatment-, Korean J Community Living Sci, 10(1), p1-6.
- Park, SJ, (1995), An experimental study on physical and chemical properties of the fabrics dyed with persimmon juice, J Korean Soc Cloth Text, 19(6), p955-967.
- Park, SJ, (2012a), Eco-Clothing, Kyungchoonsa, Seoul, p1-4.
- Park, SJ, (2012b), A study on the developmemt of persimmon juice dyed printed-fabrics following the printing method and a comparative study of the properties, Korean J Community Living Sci, 23(3), p317-328.
- Park, SJ, Park, DJ, (2002), Effect of Opuntia Ficus-indica variety Saboten Makino and Satsuma Mandarin dyeing on physical characteristics and colors of protein fabrics, J Korean Soc of Cloth Text, 26(3/4), p473-484.
- Sa, AN, Choi, HJ, Lee, JS, (2014), Combination dyeing of Chinensis and Terminalla Chebula Retzius, J Korean Soc Cloth Text, 38(3), p415-426.
- Senthilkumar, A, Joshua, AJ, BhathiI, B, Amit, A, Jung, EB, (2014), Anti-inflammatory effects of Turmeric (Curcuma longa L.) extract on acute chromic inflammation models, J Korean Soc Food Sci Nutr, 43(4), p612-617.
-
Seo, HY, Song, WS, Kim, HR, (2011), Natural dyeing with evening primrose, J Korean Soc Cloth Text, 35(2), p181-191.
[https://doi.org/10.5850/jksct.2011.35.2.181]

- Shin, JS, Chung, MH, Park, SJ, Tamura, T, Koshiba, T, (2007), Improvement of comfortability and ability on non-woven fabric disposable work clothing using yellow soil printing, Res J Costume Cult, 15(2), p276-283.
-
Shin, SY, Chung, HW, (2013), Dyeing and antimicrobial properties of cellulose and nylon fabrics treated with artemisia extracts, J Korean Soc Cloth Text, 37(8), p1130-1138.
[https://doi.org/10.5850/jksct.2013.37.8.1130]

- Shin, JS, Park, SJ, Chung, MH, Tamura, T, Koshiba, T, (2004), Characteristics changes on non-woven fabric by charcoal printing, J Korean Soc Cloth Text, 28(2), p303-311.
- Song, MK, Song, EY, (2005), The UV blocking effect of fabrics & hanji dyed with green tea, J Korean Soc Cloth Text, 29(6), p745-752.
- Sung, KC, (2011), A study on the pharmaceutical & chemical characteristics and analysis of natural curcumin extract, J Korean Oil Chemists’ Soc, 28(4), p393-401.
- Yoon, AR, (2008), Demonstration of hair dyeing effects using recycled natural hairdye, Master’s Thesis, Seokyung University, p8.
- Yoon, JY, (2009), A study on fashion design coffee dye, Master’s Thesis, Hongik University, p1-57.

